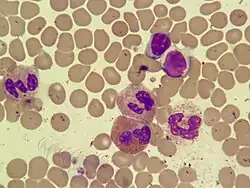

Окраска по Май-Грюнвальду
Окрашивание по Ма́й-Грю́нвальду — метод гистологической окраски, наиболее часто используемый для окрашивания микропрепаратов тонкоигольной аспирационной пункционной биопсии в гистопатологической лаборатории для диагностики опухолевых клеток. Краситель Май-Грюнвальда — это краситель на спиртовой основе, состоящий из метиленового синего и эозина. Перед окрашиванием мазок фиксируется метанолом[1].
Окрашивание по Май-Грюнвальду-Гимзе (MGG)
_MG_stain.jpg)
Чаще всего метод сочетают с окрашиванием по Гимзе, что дает окрашивание Паппенгейма (окрашивание Май-Грюнвальд-Гимзы)[2][3]. Этот метод окраски является одним из стандартных окрасок в гематологии.
Результат окрашивания:
- ядра принимают цвет от синего до фиолетово-черного;
- эритроциты розовато-бежевые;
- гранулы эозинофилов красно-оранжевые;
- гранулы нейтрофилов фиолетово-сиреневые;
- гранулы базофилов сине-черные;
- цитоплазма лимфоцитов и моноцитов принимают сине-голубую окраску[1].
См. также
Примечания
- 1 2 Piaton E., Fabre M., Goubin‐Versini I., Bretz‐Grenier M‐F., Courtade‐Saïdi M., Vincent S., Belleannée G., Thivolet F., Boutonnat J., Debaque H., Fleury‐Feith J., Vielh P., Egelé C., Bellocq J‐P., Michiels J‐F., Cochand‐Priollet B. Guidelines for May‐Grünwald–Giemsa staining in haematology and non‐gynaecological cytopathology: recommendations of the French Society of Clinical Cytology (SFCC) and of the French Association for Quality Assurance in Anatomic and Cytologic Pathology (AFAQAP) (англ.) // Cytopathology. — 2016. — 5 May (vol. 27, no. 5). — P. 359—368. — ISSN 0956-5507. — doi:10.1111/cyt.12323.
- ↑ Harald Kluge. Atlas of CSF Cytology. — Thieme, 2007. — P. 4. — ISBN 978-3-13-143161-5.
- ↑ Giorgio Gherardi. Fine-Needle Biopsy of Superficial and Deep Masses: Interventional Approach and Interpretation Methodology by Pattern Recognition. — Springer Science & Business Media, 14 August 2010. — P. 10. — ISBN 978-88-470-1433-6.